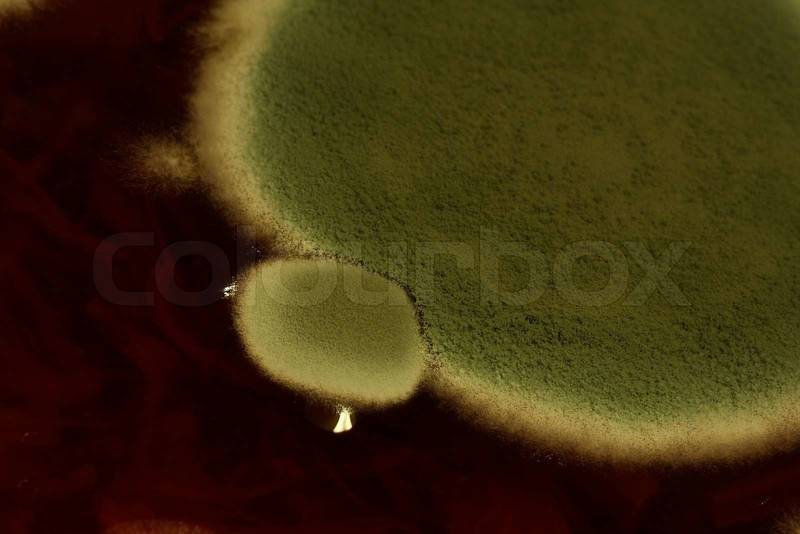
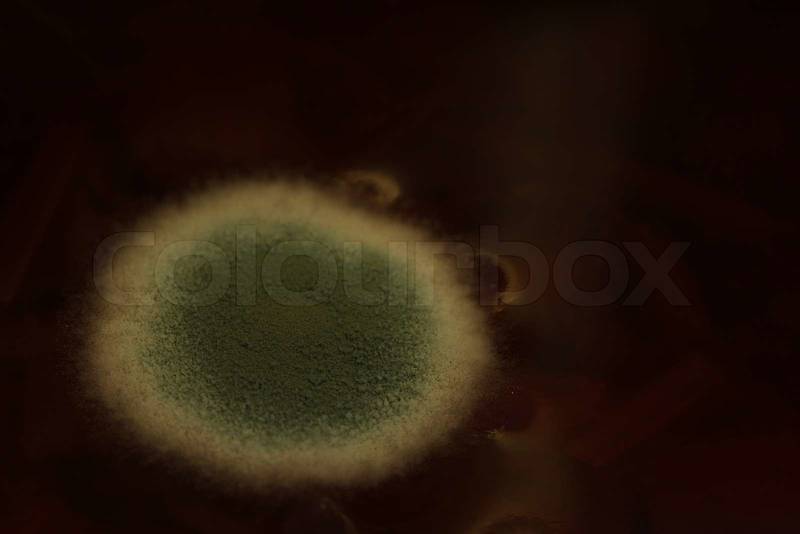

Tipo de archivo
: Cualquiera
: Fotos
: Vectores
: Videos
Ordenar por
: Aleatorio
: Selección de Colourbox
: Más recientes
Orientación
: Cualquiera
: Horizontal
: Vertical
Licencia
: Stock
: Editorial
Resolución
: Cualquiera
: Mín. A4 a 300 dpi
: Mín. A3 a 300 dpi
Color
: Cualquiera
Búsqueda segura
: Activado
: Desactivado
Tamaño de visualización